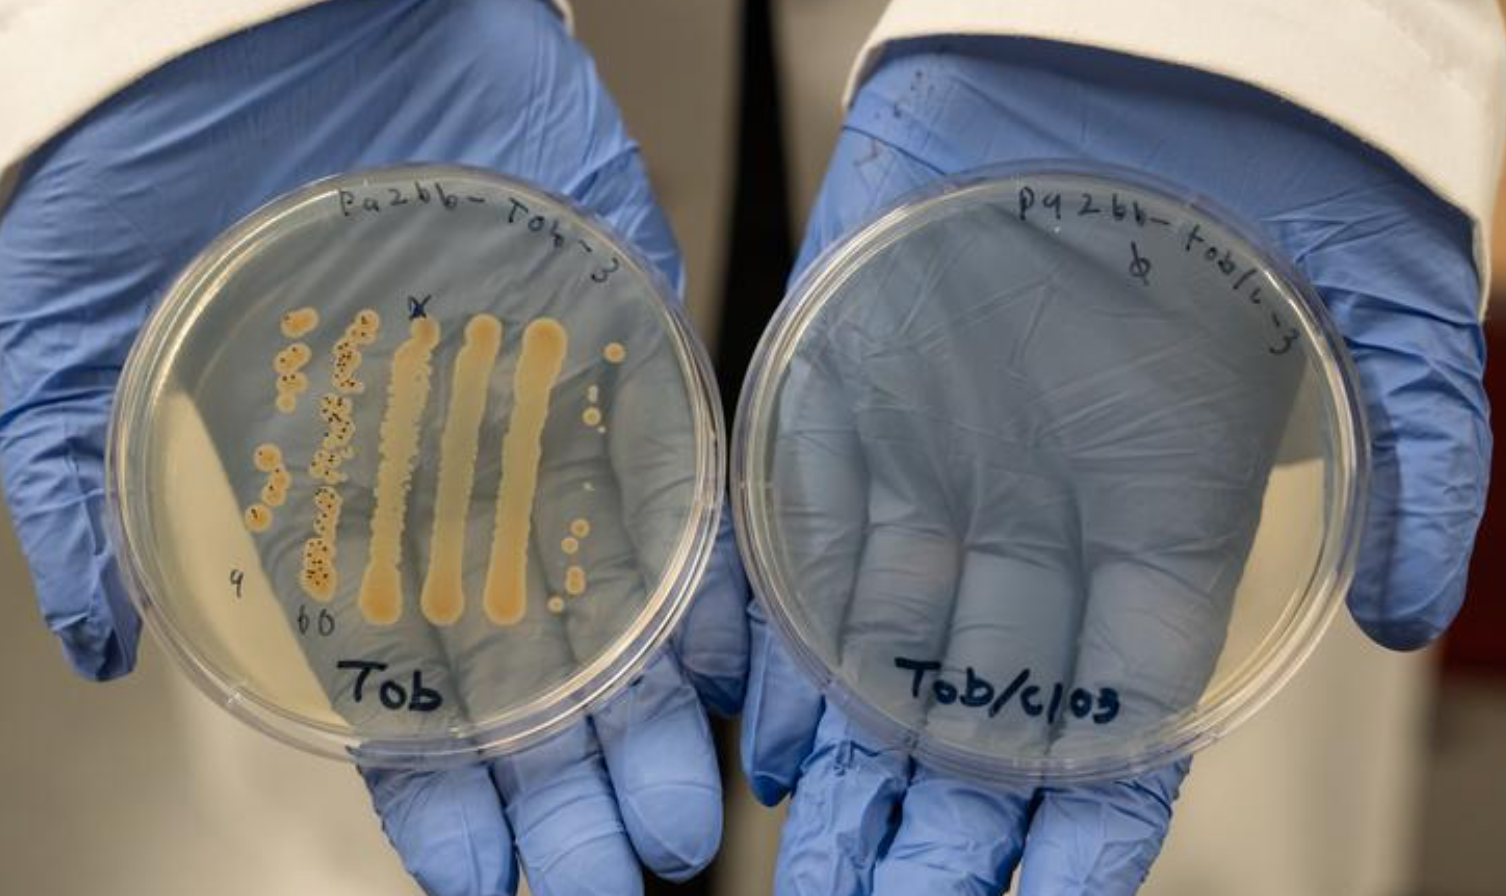

University of Oregon investigators have found that by adding small doses of chlorate to standard antibiotics, the combination proved 10,000 times more effective at killing bacterial cells in the lab than single-drug antibiotics. They tested the drug combination on the pathogenic bacterium P aeruginosa, which commonly infects chronic wounds.
Image credit: Nicolas Walcott, University of Oregon
Investigators from the University of Oregon have discovered that pairing standard antibiotics with chlorate can dramatically improve the treatment of chronic wound infections.1
In lab tests, the combination therapy was 10,000 times more effective at killing Pseudomonas aeruginosa, than antibiotics alone. Investigators say this approach has the potential to shorten treatment times, lower drug toxicity, and help patients avoid severe complications.1
The findings were published earlier this week in Applied and Environmental Microbiology.
“Drug combinations will be a critical way to outpace resistance,” Melanie Spero, assistant professor of biology and senior author, said in an interview with Oregon News. “Chlorate stresses bacteria in a way that makes them vulnerable to antibiotics we already have.”2
What You Need to Know
Pairing the compound chlorate with standard antibiotics made them up to 10,000 times more effective against Pseudomonas aeruginosa in lab tests.
The approach could lower the antibiotic doses patients need, minimizing side effects and shortening treatment times for chronic wounds.
Beyond wound care, this strategy may offer a new path to combat antibiotic resistance by repurposing drugs already on the market
Chronic Wounds: Hard to Treat
Chronic wounds, which can be characterized as injuries that don’t heal within 4 to 12 weeks, are common in people with diabetes. Up to 1 in 4 patients with type 2 diabetes develops a foot ulcer, and half of those wounds become infected. Severe cases may require amputation.2
Low oxygen levels inside chronic wounds create conditions where bacteria grow slowly, making them resistant to drugs designed to kill fast-growing cells. Standard antibiotics often fail under these conditions.2
Boosting Existing Drugs
Chlorate, a simple chemical, which is harmless to humans in the small doses used in the study, interferes with bacterial respiration under low-oxygen conditions. When combined with antibiotics like ceftazidime, the investigators were able to use just 1% of the standard antibiotic dose to achieve the same killing effect in the lab.2
Because long-term, high-dose antibiotic use can damage gut microbes and cause severe side effects, the ability to lower doses could have major clinical benefits.2
Next Steps
While the results are based on cell cultures, Spero’s team aims to study how the therapy works in more complex microbial communities, such as those found in chronic infections. The group also plans to investigate the underlying mechanisms of how chlorate makes bacteria more vulnerable.2
“This work has implications not only for chronic wound care but for the broader fight against antibiotic resistance,” Spero said. “Once we understand the biology behind drug synergy, we can move toward smarter, more targeted therapies.”2